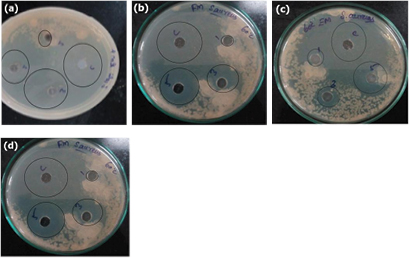
Figure 6.

Abstract
Mushroom has been part of the human diet for thousands of years, and in recent times, the amounts consumed have risen greatly, involving a large number of species. Mushrooms used for nutritional and therapeutic purposes. In this study silver nanoparticles were synthesised using an edible mushroom (Agaricus bisporus) and forest mushroom (Ganoderma lucidum) extract. The synthesised nanoparticles were characterised by UV–vis spectroscopy, FTIR, powder XRD and SEM. Silver nanoparticles were synthesised at room temperature and at 60 °C. FTIR results recognised the presence of bioactive functional groups responsible for the reduction of silver nitrate to silver nanoparticles. From the XRD, it was observed that the nanoparticles are silver with an average size of 10–80 nm. The silver nanoparticles are explored for photocatalytic activity and biological activities such as in vitro antioxidant activity, anti-inflammatory activity and antimicrobial activity against Escherichia coli and Staphylococcus aureus organisms. 98% of textile dye (direct blue 71) degradation was noticed under UV light within 150 min for forest mushroom synthesised silver nanoparticles at room temperature.
Export citation and abstract BibTeX RIS

Original content from this work may be used under the terms of the Creative Commons Attribution 3.0 licence. Any further distribution of this work must maintain attribution to the author(s) and the title of the work, journal citation and DOI.
1. Introduction
In recent years, nanotechnology has played a significant role in drug delivery, bio therapeutics, pharmaceutical, electronics, cosmetics, biotechnology, nano fertilizers, ointments, creams and water treatment etc [1, 2]. Nanoparticles are synthesized by three different methods such as physical, chemical and biological methods. The biosynthesis is cost effective, simple and biocompatible when compared to physical and chemical methods. It produces an excellent platform for environmentally benign synthesis of nanoparticles to improve the properties. Microorganisms such as bacteria, fungi, actinomycetes, algae and plant extracts are used as reducing agent for the synthesis of metal nanoparticles [3]. Biosynthesized silver nanoparticles (AgNPs) are studied with remarkable applications [4].
Alireza et al [5] studied anticancer and antimicrobial activity of silver nanoparticles using Cholrella vulgaris (algae). Algae acted as a capping and reducing agent for synthesis of silver nanoparticles. Extract of endophytic fungi, Penicillium species of Glycosmis mauritiana is reported for the antioxidant, anti-inflammatory activity [6]. AgNPs synthesised from carambola fruit extract studied for antimicrobial activity [7]. Many other researchers have reported the synthesis of silver nanoparticles from Solidago altissima extract [8], aqueous extract of Chamaemelum nobile [9], alkalinized leaf extract of Cymbopogon citrates [10]. The advantages of plant and organisms mediated silver nanoparticles are eco-friendly, safe to handle and having variety of secondary metabolites which acts as a reducing and capping agent for synthesis of silver nanoparticles [6].
Furthermore, many fungi such as Agaricus bisporus, Calocybe indica, Pleurotus florida and Pleurotus platypus [11], Tricholoma matsutake [12], Schizophyllum commune [13], Volvariella volvacea [14] Pleurotus florida [15], Ganoderma neo-japanicum imazeki [12], Lentinula edodes [11], Hypsizigus marmoreus [16] have been reported for the synthesis of metal nanoparticles. The massive production of nanoparticles are achievable in the presence of fungi when compared to bacteria; fungal enzymes are responsible for the secretion of a greater percentage of nanoparticles [17]. Mushroom is rich in amino acids, vitamins and proteins, low in calories, fats and essential fatty acids [18] Mushrooms are well known to have anticancer, anti-inflammatory, antioxidant, cardiovascular, antibacterial, hypertensive and hepatoprotective applications in biological systems [19]. The various types of mushroom are well known and, it produces fleshy fruit bodies. For example, Agaricus, Pleurotus and Volvariella [20]. Ganoderma lucidum (forest mushroom), Agaricus bisporus (an edible mushroom) are well known for its antioxidant, anti-inflammatory, antimicrobial activity [21]. The synthesis of silver nanoparticles was reported using pine mushroom, a natural forest mushroom [12], the edible mushroom synthesised silver and gold nanoparticles with size ranges from 10–70 nm was reported [22]. High content of protein presented in the mushroom extract [23].
In the human system, passive and adaptive immune systems are responsible for inflammation. Moreover, unchecked inflammation causes anti-inflammatory disorder, neurogenerative disease, rheumatoid arthritis and cancer. Aspirin and other antisteroid hormones are used as effective anti-inflammatory drugs and some more drugs are under the development [24]. Nowadays many researchers are analysing the antioxidant activity of edible and wild mushroom due to its total phenolic contents. Metallic nanoparticles are widely used as the antimicrobial agent for example, silver nanoparticles have been used in bone cement, wound dressing and implantation [21, 25]. Silver nanoparticles are non-toxic to human beings and most efficient against microorganisms at low concentration and no side effects [26]. Moreover, silver and silver salts derivatives are commercially manufactured as antimicrobial agents [27]. Lesser concentrations of silver are safe for human cells but effective for microorganisms [28]. Mushroom has more antioxidant compounds [29]. Mushroom made up a mixture of secondary metabolites including terpenoids, polyketides, steroids and phenolic compounds. These phenolic compounds are responsible for antioxidant activity and inhibition of LDL oxidation [30]. Image of forest and edible mushroom are shown in figure 1.
Figure 1. Photographs of (a) forest and (b) edible mushroom.
Download figure:
Standard image High-resolution imageTextile dye is a rich source of toxic organic compounds it causes environmental pollution. Direct blue is one among the textiles dyes, which is a water-soluble anionic azo dye. The empirical formula of direct blue 71 is C40H28N7NaO13S4. The textile dye enters into the soil and water bodies, affects the ecosystem and causes environmental hazards [31]. The accumulation of water bodies (nutrients) and textile dyes causes eutrophication and reduces reoxygenation capacity and does severe damage to the aquatic microorganisms [32]. Dyes are degraded by many methods such as ultrafiltration, adsorption and chemical method [33]. In the recent years, researchers are focussing on the photocatalytic degradation of dyes using metallic nanoparticles [34]. Trigonella foenum-graecum seeds [35], Ulva lactuca [36], Hypnea musciformis [37] synthesised silver nanoparticles are reported for degradation of methyl orange.
In the present work AgNPs are synthesised using forest mushroom (FRT) and edible mushroom (ERT) at room temperature and also at 60 °C using forest mushroom (FHT) and edible mushroom (EHT). The synthesised nanoparticles AgNPs by FRT, ERT, FHT and EHT, are characterised, and its antioxidant, anti-inflammatory and photocatalytic degradation of direct blue 71 dye are studied and compared.
2. Materials and method
The forest mushroom was collected from the odugathur area (12.7687° N, 78.8818°), Vellore district, Tamilnadu, India during the month of June 2016. The edible mushroom was commercially available in Allmart, Vellore, Tamilnadu. Silver nitrate, aceclofenac and 1,1-diphenyl-2-picrylhydrazyl (N 99.5%) was purchased from Sigma-Aldrich, Chennai. Textile dye was purchased from R K Industries, Tripur.
2.1. Preparation of mushroom extract
Fresh Ganoderma lucidium (forest mushroom) and Agaricus bisporus (edible mushroom) were collected and thoroughly washed with distilled water. The mushrooms were kept in shade region for 4 days and then powdered. 1 g of powdered mushrooms was taken and 100 ml of distilled water was added and kept in stirrer for 60 min. The extract solution was filtered using Whatman filter paper. The aqueous extract was collected and used for the synthesis of silver nanoparticles.
2.2. Synthesis of silver nanoparticles at room temperature
In the synthesis of silver nanoparticles, 10 ml of the mushroom extract (forest mushroom (FRT) or edible mushroom (ERT)) was added to 90 ml of 1 mM silver nitrate solution. This solution was kept at room temperature for 12 h. After keeping for 12 h silver nanoparticles obtained as a solid precipitate. The colour change from colourless to brown colour is observed. After the centrifugation the precipitated silver nanoparticles are collected.
2.3. Synthesis of silver nanoparticles at 60 °C
90 ml of 1 mM silver nitrate solution and 10 ml of aqueous mushroom extract (forest mushroom (FHT) or edible mushroom (EHT)) was heated at 60 °C for 5 h. After heating the colloidal solution was produced, this solution was centrifuged at 5000 rpm for 20 min and allow to AgNPs are settling down. The obtained silver nanoparticles are used further for characterization and applications.
2.4. Biological analysis
2.4.1. Antibacterial activity
The antibacterial activity of mushroom synthesised silver nanoparticles was carried out by the well diffusion method against Escherichia coli (gram negative bacteria), Staphylococcus aureus (gram-positive bacteria). Muller Hinton agar plates were prepared and solidified. After solidification, the bacterial culture such as E. coli, S. aureus were spread on the plate by using a sterilised cotton swab. 0.5 cm well was made in the medium by using sterile cork borer, 25 µl, 50 µl, 100 µl of AgNPs were loaded into the each well. These plates were incubated at 37 °C for 24 h incubation. The wells were loaded with an equal volume of antibiotic solution (as a control). The clear zone formation indicates the antimicrobial activity.
2.4.2. Anti-inflammatory activity
The anti-inflammatory activity was done by heat-induced hemolysis method [34, 38] using methanol as a standard. 5 ml blood sample was collected from human and centrifuged at 3000 rpm for 15 min, cells were washed with saline (pH 7.21). Equal volume of (200 µl) silver nanoparticles of various concentration (25%, 50%, 100% concentration) and 400 µl 10% RBC suspension was transferred in centrifuge tube. 3 ml of methanol was added into all centrifuge tube and kept in a water bath for 30 min. The absorbance (520 nm) was monitored using UV spectrophotometer at 10 min intervals. Saline containing aceclofenac drug was taken as control.
2.4.3. Antioxidant activity
The antioxidant activity was determined by 2,2-diphenyl-1-picrylhydrazyl (DPPH) free radical method. An equal volume of (200 µl) silver nanoparticle of various concentrations (25%, 50%, and 100%) was mixed with 3 ml of a methanol solution containing DPPH. The nanoparticles mixture was shaken aggressively and kept for 60 min in dark place. After 60 min, the reduction of DPPH radicals was monitored using UV spectrophotometer by measuring the absorption at 517 nm. Aceclofenac used as a control. Following formula was used to analyse the percentage inhibition of DPPH scavengers:

where A1 is absorbance of blank, A2 is absorbance of sample and A0 is absorbance of control.
2.5. Photocatalytic activity
The photocatalytic activity of the forest and edible mushroom synthesised silver nanoparticles were estimated for the degradation of direct blue 71 dye. Photocatalytic activities were carried out under UV light (265 nm). For the photocatalytic experiment, 10 mg of photocatalyst was suspended in 10 ppm of direct blue 71 dye (50 ml). The suspension was magnetically stirred in dark exposure for 1 h to reach the adsorption/desorption equilibrium. Photocatalytic degradation was started by exposing the suspension to UV light. 3 ml of suspension was withdrawn at regular intervals (30 min), centrifuged and analysed using UV–vis spectroscopy. The decrease of the intensity of the absorption peak (591 nm) of the direct blue 71 dye was a measure of the dye degradation. The dye degradation was calculated using the following equation

where C0 is the initial concentration of the direct blue 71 dye solution, Ct is the concentration of the dye solution after UV light exposure.
2.6. Characterization
The formation of silver nanoparticles was monitored using UV–vis spectroscopy (JASCO model V-670), IR spectroscopy (JEOL 2100). Phase identification was carried out by powder XRD analysis (Bruker D8 instrument, Germany). Surface and morphological characterization analysis using SEM (Carl Zeiss EVO 18, Germany). Statistical analysis of FHT, FRT, EHT, and ERT synthesised silver nanoparticles activities data were analysed using ANOVA test followed by T-test. p values were calculated for each data and interpretation was carried out for each sample.
3. Results and discussion
The fungal synthesised nanoparticles are more stable and non-toxic compared to plant and other organism synthesised nanoparticles is reported in [4]. Optimum time and temperature plays a vital role in nanoparticles formation [1]. Mushrooms are well known for rich protein content food consisting of 75% proteins [35]. The aqueous mushroom extract is rich in protein, and also the availability of lysine, amino acid, tryptophan and glutamic acid are more [39]. Mushroom extracts serve as an excellent source of riboflavin and other nutrients [40]. Bhat et al [15] suggested that the flavoproteins presented into the mushroom extracts are responsible for the formation of silver nanoparticles. Similarly, Anthony et al [12] also reported the same flavoproteins are responsible for the synthesis of silver nanoparticles using pine mushroom. These reports suggest that the specific biomolecules (proteins and other nutrients) in mushroom is responsible for the synthesis of silver nanoparticles.
3.1. UV–vis spectroscopy
The surface plasmon resonance of aqueous solution of silver nanoparticles synthesised at different conditions is given in figure 2. FRT showed the peak at 434 nm, and FHT showed at 422 nm. Both ERT and EHT showed the peak at 414 nm in the UV spectrum. These results clearly illustrate that the synthesised compounds are AgNPs. Effect of temperature on the synthesis of AgNPs are reported in [7] by using carambola fruit extract. Increase in absorbance and decrease in size of the nanoparticles are observed [7]. But in the present work not much change in the absorbance is noted with respect to temperature. Rao et al [41] reported the absorbance peaks at 420, 430 and 435 nm for AgNPs synthesised using Boswellia ovaliofoliolata, Shorea tumbuggaia and Svensonia hyderobadensia, respectively. Bala and Arya [42] synthesised AgNPs from Aspergillus fumigatus and confirmed it by surface plasmon resonance at 450 nm. The current results are agreed with the literature.
Figure 2. UV–vis spectra of (a) EHT, ERT and (b) FHT, FRT synthesised silver nanoparticles at various temperatures.
Download figure:
Standard image High-resolution image3.2. FTIR spectroscopy
The FTIR spectra of the AgNPs were recorded to identify the functional groups involved in the synthesis of AgNPs which is shown in figure 3. The presence of flavonoids and alkaloids in the mushroom extract could be responsible for the reduction of silver ions to AgNPs [12]. Overall observation from FTIR peak confirms the bioactive component in charge for the synthesis of AgNPs. The peak at 3304–3340 confirms the presence of –OH group. The peak at 2923 indicates C–H stretching. The band around 1620 is due to the amide C=O stretch. The band near at 1350–1400 is assigned for alkane –C–H– bond. The band at 1000–1050 represents the C–O–C stretching. Amines, carboxylic acids, aldehydes, alkane are the functional groups mainly presented in the plant and microorganisms which are responsible for synthesis silver nanoparticles [9].
Figure 3. FTIR analysis of AgNPs using (a) EHT, ERT and (b) FHT, FRT mushroom extract synthesised silver nanoparticles.
Download figure:
Standard image High-resolution image3.3. Powder XRD
To confirm the formation of silver nanoparticles powder XRD was recorded. Figure 4(a) represents the XRD pattern of FHT and FRT synthesised silver nanoparticles. Figure 4(b) exhibit EHT, ERT synthesised silver nanoparticles. Diffraction peaks are observed at 38.1°, 44.6°, 64.3° and 78.5° which corresponds to the (1 1 1), (2 0 0), (2 2 0), and (3 1 1) reflection planes of cubic centred silver nanoparticles (JCPDS NO: 87-0720). These results were similar to Andrographis paniculata, Alstonia scholaris, Centella Asiatica synthesised silver nanoparticles [2]. Additional peaks are also observed in the XRD pattern of silver nanoparticles due to the constituents in mushroom extract responsible for resultant of silver nanoparticles. XRD results are consistent with Prasannaraj and Venkatachalam [2]. The crystalline structure of nanoparticles and its corresponding plane values are reported earlier [3, 43].
Figure 4. XRD patterns of (a) FHT, (b) FRT, (c) EHT and (d) ERT synthesised silver nanoparticles.
Download figure:
Standard image High-resolution image3.4. Scanning electron microscopy
The surface morphology of the synthesised silver nanoparticles was studied using scanning electron microscopy. FRT synthesised nanoparticles shows small rod-shaped nanoparticles FHT synthesised silver nanoparticles are agglomerated needle-like structure. ERT and EHT nanoparticles are also agglomerated with a sponge-like structure (figure 5). Size and shapes of the silver nanoparticles are affected by pH, temperature, incubation time and reductant concentration and method of preparation. Aegle marmelos, Andrographis peniculata and A. scholaris mediated silver nanoparticles are reported with various shapes such as rectangular and spherical and various sizes based on temperature and pH [2].
Figure 5. SEM images of (a) FRT (b) FHT (c) ERT (d) EHT mushroom synthesised silver nanoparticles.
Download figure:
Standard image High-resolution image3.5. Antimicrobial activity
The antimicrobial effect of AgNPs has been well known and found a routine use in the pharmaceutical industry for anti-infection related applications [44]. In this paper, we are interested in studying the antibacterial activity of mushroom synthesised AgNPs against S. aureus and E. coli bacteria (figure 6). 100 µl of forest mushroom extracts (FHT, FRT) inhibited the growth of S. aureus (24 mm) and E. coli (28 mm). Edible mushroom extracts (EHT, ERT) show a good zone of inhibition for E. coli (26 mm) and S. aureus (22 mm). So these nanoparticles represent the effective antibacterial activity for both gram positive (S. aureus) and gram negative (E. coli) organisms. Erythromycin is used as a standard drug. Based on cell wall composition and structure of microorganisms, different zone of inhibition will be obtained [6, 9]. Mane Gavade et al reported 26 mm for E. coli and 8 mm for Pesudomonas aeroginosa using silver nanoparticles [7]. The results of the current work are concurring with the researchers working on AgNPs. Mushroom extracted synthesised AgNPs presented more antibacterial activity when compared to fruit and plant extract synthesised nanoparticles. Govindappa et al [6] proposed the antimicrobial activity of AgNPs could be due to cell death including lose of replication and cellular protein inactivation. When compared to S. aureus antimicrobial activity of AgNPs against E. coli is found to be excellent. AgNPs have unrestricted silver ions these ions are bind to the pathogenic microorganisms' cell wall and leads to cell death [5].
Figure 6. Antimicrobial activity of (a) FHT (b) FRT (c) ERT (d) EHT synthesised silver nanoparticles.
Download figure:
Standard image High-resolution image3.6. Anti-inflammatory activity
The in vitro anti-inflammatory activity was studied for forest, and edible mushroom synthesised AgNPs nanoparticles. The results are summarised in table 1. EHT synthesised AgNPs shows higher protection activity (84% ± 0.25%) when compared to ERT, FHT and FRT synthesised AgNPs. This activity was compared to that of aceclofenac antibiotic (standard). Similar results are observed by Govindappa et al for silver nanoparticles synthesized using Penicillium sp. (83.6% ± 1.4%) [6]. Less than 0.05 p values denote that FHT, FRT, EHT and ERT synthesised AgNPs is found to have best anti-inflammatory activity. Statistical analysis of the anti-inflammatory activity of mushrooms synthesised AgNPs are tabulated in table S1 (see supplementary information) (stacks.iop.org/ANSN/8/045012/mmedia).
Table 1. Anti-inflammatory activity of forest mushroom and edible mushroom synthesised silver nanoparticles.
| Compound name | Protection ± SD (%) | p-value | Error value |
|---|---|---|---|
| FHT | 83 ± 0.31 | 0.00 | 0.116 |
| FRT | 80 ± 0.26 | 0.03 | 0.098 |
| EHT | 84 ± 0.25 | 0.00 | 0.088 |
| ERT | 75 ± 0.23 | 0.00 | 0.089 |
| Standard | 87 ± 0.24 | 0.01 | 0.084 |
| Control | No inhibition | — | — |
Note: standard is aceclofenac, control is methanol, and results considered significant p > 0.05.
3.7. Anti-oxidant activity
Anti-oxidant activity of FHT, FRT, EHT, ERT synthesised silver nanoparticles are shown in table 2. Similar to anti-inflammatory results, among all the sources EHT synthesised AgNPs shows higher antioxidant activity (75% ± 0.24%) compared to standard (70.34% ± 0.03%). p value less than 0.05 indicates that the anti-oxidant activity of FHT, FRT, EHT, ERT synthesised AgNPs is more. Emmanuel and Afolayan reported 70% antioxidant property for silver nanoparticles synthesized using Cymbopogon citrates aqueous extracts [10]. But in the current work 75% of antioxidant activity is observed with EHT synthesized silver nanoparticles. Chaga mushroom synthesised silver nanoparticles are reported for antioxidant activity with a protection value of 76.57% [45]. Plant extracted AgNPs shown lesser acivity compared to mushroom synthesised AgNPs [10, 45]. Pictographic representation of the anti-oxidant activity of AgNPs is shown in figure 7 and statistical analysis of anti-oxidant activity is given in table S2 (see supplementary information). The biologically active compounds such as phenolic and flavonoid compounds are main agents for the antioxidant activity they can donate hydrogen to free radicals and break the lipid oxidation chain reaction [45].
Table 2. Antioxidant activities of forest mushroom and edible mushroom synthesised silver nanoparticles.
| Compound name | Protection ± SD (%) | p-value | Error value |
|---|---|---|---|
| FHT | 60 ± 0.17 | 0.03 | 0.064 |
| FRT | 49 ± 0.17 | 0.01 | 0.062 |
| EHT | 75 ± 0.24 | 0.00 | 0.089 |
| ERT | 54 ± 0.07 | 0.00 | 0.099 |
| Standard | 70.34 ± 0.03 | 0.03 | 0.083 |
| Control | No inhibition | — | — |
Note: standard is aceclofenac, control is methanol, and results considered significant p > 0.05.
Figure 7. Anti-oxidant activity (%) of silver nanoparticles in different mushrooms.
Download figure:
Standard image High-resolution image3.8. Photocatalytic activity
Photocatalytic activities of AgNPs have been examined by performing the degradation of direct blue 71 dye (10 ppm) under UV light irradiation. The characteristic absorption peak for direct blue 71 solutions was observed at 595 nm in the UV–vis spectroscopy. The degradation of the direct blue solution was visualised by a decrease in the intensity of the 595 nm (figure 8). Compared to forest mushroom synthesised nanoparticles EHT and ERT, edible mushroom synthesised nanoparticles FRT showed higher degradation efficiency (97%) in 150 min (figure 9). Degradation of FHT, FRT, EHT and ERT synthesised AgNPs are summarised in table S3. Saien and Soleyami also reported the similar percentage of degradation of this dye using titanium oxide nanoparticles [46]. Kumar et al [8] reported photocatalytic activity of silver and silver chloride composed nanoparticles using weed Solidago altissima (goldenrod) against rhodamine B dye. Nashwa et al [47] reported 100% decolorization efficiency of direct blue 71 azo dye in the presence of nano zero valent iron catalyst after 48 h. Absorbance graph for FHT, EHT, and ERT synthesised silver nanoparticles are depicted in figures S1–S3 (see supplementary information).
Figure 8. UV–vis analysis of FRT synthesised silver nanoparticles dye degradation.
Download figure:
Standard image High-resolution imageFigure 9. Dye degradation using mushroom synthesised nanoparticles.
Download figure:
Standard image High-resolution image4. Conclusion
Silver nanoparticles are successfully synthesised by cost-effective, eco-friendly method using Ganoderma lucidum and Agaricus bisporus aqueous extracts. The formation of mushroom synthesised FHT, FRT, EHT and ERT nanoparticles confirmed by XRD and UV–vis spectroscopy. FTIR spectrum evidences the biomolecules present in mushroom which acts as reducing and capping agent in the synthesis of nanoparticles. The biosynthesised AgNPs are non-toxic (p < 0.05) and excellent anti-inflammatory and anti-oxidant activities are noted for EHT. The zone of inhibition proves silver nanoparticles has good antibacterial activity against E. coli and S. aureus. 97% direct blue 71 dye degradation was achieved within 60 min using FRT synthesised AgNPs. Antimicrobial activity and photo catalytic activity determine that silver nanoparticles have outstanding applications in waste water treatment.
Acknowledgment
We would like to thank VIT University, Vellore for providing required lab facilities and financial assistance.